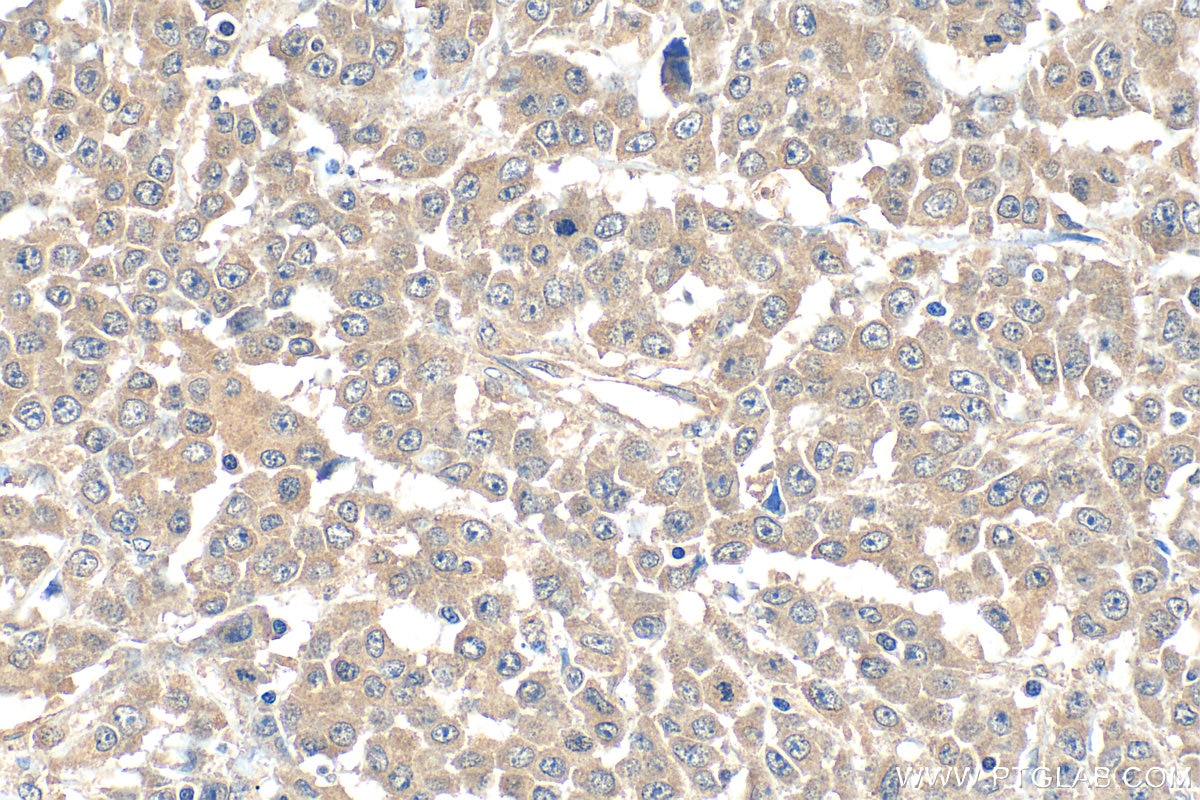

Tested Applications
| Positive IHC detected in | human colon cancer tissue Note: suggested antigen retrieval with TE buffer pH 9.0; (*) Alternatively, antigen retrieval may be performed with citrate buffer pH 6.0 |
Recommended dilution
| Application | Dilution |
|---|---|
| Immunohistochemistry (IHC) | IHC : 1:20-1:200 |
| It is recommended that this reagent should be titrated in each testing system to obtain optimal results. | |
| Sample-dependent, Check data in validation data gallery. | |
Published Applications
| KD/KO | See 1 publications below |
| WB | See 7 publications below |
| IHC | See 2 publications below |
| IF | See 3 publications below |
| CoIP | See 1 publications below |
Product Information
11780-1-AP targets TRAF7 in WB, IHC, IF, CoIP, ELISA applications and shows reactivity with human samples.
| Tested Reactivity | human |
| Cited Reactivity | human, mouse, rat, zebrafish |
| Host / Isotype | Rabbit / IgG |
| Class | Polyclonal |
| Type | Antibody |
| Immunogen |
CatNo: Ag2414 Product name: Recombinant human TRAF7 protein Source: e coli.-derived, PGEX-4T Tag: GST Domain: 70-420 aa of BC024267 Sequence: QAALQDSMPPISTPRRSDSAISVRSLHSESSMSLRSTFSLPEEEEEPEPLVFAEQPSVKLCCQLCCSVFKDPVITTCGHTFCRRCALKSEKCPVDNVKLTVVVNNIAVAEQIGELFIHCRHGCRVAGSGKPPIFEVDPRGCPFTIKLSARKDHEGSCDYRPVRCPNNPSCPPLLRMNLEAHLKECEHIKCPHSKYGCTFIGNQDTYETHLETCRFEGLKEFLQQTDDRFHEMHVALAQKDQEIAFLRSMLGKLSEKIDQLEKSLELKFDVLDENQSKLSEDLMEFRRDASMLNDELSHINARLNMGILGSYDPQQIFKCKGTFVGHQGPVWCLCVYSMGDLLFSGSSDKTI Predict reactive species |
| Full Name | TNF receptor-associated factor 7 |
| Calculated Molecular Weight | 75 kDa |
| Observed Molecular Weight | 67-75 kDa |
| GenBank Accession Number | BC024267 |
| Gene Symbol | TRAF7 |
| Gene ID (NCBI) | 84231 |
| RRID | AB_2877793 |
| Conjugate | Unconjugated |
| Form | Liquid |
| Purification Method | Antigen affinity purification |
| UNIPROT ID | Q6Q0C0 |
| Storage Buffer | PBS with 0.02% sodium azide and 50% glycerol, pH 7.3. |
| Storage Conditions | Store at -20°C. Stable for one year after shipment. Aliquoting is unnecessary for -20oC storage. 20ul sizes contain 0.1% BSA. |
Protocols
| Product Specific Protocols | |
|---|---|
| IHC protocol for TRAF7 antibody 11780-1-AP | Download protocol |
| Standard Protocols | |
|---|---|
| Click here to view our Standard Protocols |
Publications
| Species | Application | Title |
|---|---|---|
Kidney Int Copy number variation analysis identifies novel CAKUT candidate genes in children with a solitary functioning kidney. | ||
Mol Ther Nucleic Acids HFD-induced TRAF6 upregulation promotes liver cholesterol accumulation and fatty liver development via EZH2-mediated miR-429/PPARα axis. | ||
Virol Sin TRAF7 negatively regulates the RLR signaling pathway by facilitating the K48-linked ubiquitination of TBK1
| ||
Cell Death Discov TRAF7-targeted HOXA5 acts as a tumor suppressor in prostate cancer progression and stemness via transcriptionally activating SPRY2 and regulating MEK/ERK signaling | ||
Free Radic Biol Med Hydrogen sulfide improves endothelial barrier function by modulating the ubiquitination degradation of KLF4 through TRAF7 S-sulfhydration in diabetic aorta | ||
Genes (Basel) Expression of Congenital Anomalies of the Kidney and Urinary Tract (CAKUT) Candidate Genes EDA2R, PCDH9, and TRAF7 in Normal Human Kidney Development and CAKUT |